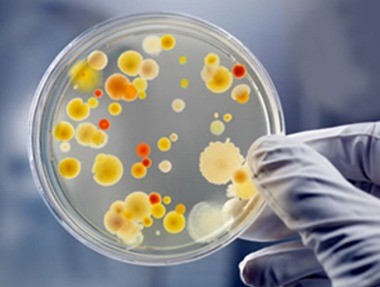

Description
We are offering Agro producers and exporters a sterilisation service in order to meet international quality standards by reducing macro-bacteria count in Agro products using our advanced sterilisation line.
Overview services
We are offering Agro producers and exporters a sterilisation service in order to meet international quality standards by reducing macro-bacteria count in Agro products using our advanced sterilisation line.

